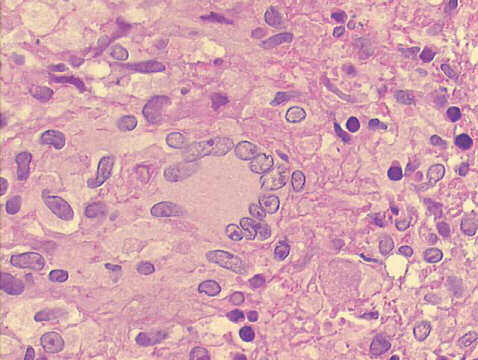
500x H&E staining, detail of Langhans multinucleated histiocyte

The pleural fluid sediment revealed the presence of many lymphocytes (approximately 95% of the cells present), some epithelioid cells, a few Langhans type of multinucleated histiocytes, and no mesothelial cells. A pleural biopsy showed granulomatous pleuritis, with positive Ziehl-Neelsen staining for acid fast bacilli. Cultures were positive for M. tuberculosis.
Lymphocytes in excess of 95% of the cellular content, and absence of mesothelial cells, are findings highly suggestive of tuberculosis in serous effusions. The presence of epithelioid cells, and Langhans cells are quite rare in cytological specimens of tuberculous pleuritis.

| Case B May 2003 | Case C May 2003 | References |
|
Atlas |